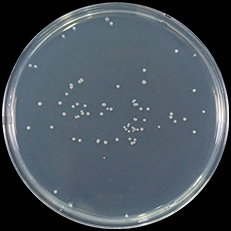

この商品を
比較リストに
追加する



ガンコな汚れを、濃度の高い洗剤液と
強力な水流ですっきり落とす。










※当社調べ。2020年モデルBW-DKX120F(BW-DX120Jと同等性能の機種)、洗濯7.2kg(6割負荷)時、標準コースにおいて。衣類の量、汚れ、洗剤、コースの種類などによって効果は異なります。※泥汚れは人工的に付着させたものです。
高低差を減らしたビートスロープで、
衣類の負荷を低減し、布傷みを抑える。


















※当社調べ。ビートウィングプラス未搭載2021年モデルBW-X120Gと2022年モデルBW-X120H(BW-DX120Jと同等性能の機種)の比較。洗濯7.2kg(6割負荷)時、標準コース50回運転において。※衣類の量、汚れ、洗剤、コースの種類などによって効果は異なります。

洗剤を少ない水で溶かして、洗剤の力を引き出した高濃度洗剤液を作成。[ビートウィングプラス]の中央にあるセンターウィングが生み出す[スピード浸透水流]により、衣類に高濃度洗剤液をすばやく浸透。高い洗浄力はそのままに、スピーディーに洗い上げます。さらに、高低差を減らしたビートスロープで衣類をやさしく入れ替え、布傷みを抑えます。
高い洗浄力はそのままに、
スピーディーに洗い上げる。

洗剤を少ない水で溶かし、
高濃度洗剤液をつくる

※洗剤投入経路は機種によって異なります。
界面活性剤は濃度が高いと、油汚れを多く取り込める。

イメージ図
[スピード浸透水流]で
高濃度洗剤液の浸透を促進

センターウィングで中央からも循環水を引き込み、槽内の衣類全体に洗剤液の浸透を促進し、洗いムラを低減

ビートウィングプラスで
押して+たたいて+もみ洗う

洗剤液を循環させて
衣類にたっぷり散布










※当社調べ。BW-DX120J、洗濯2kg時、温水180分において。衣類の汚れは人工皮脂によるものです。衣類の量、汚れ、洗剤の種類などによって効果は異なります。

ニオイの原因菌もすっきり
培養したニオイの原因菌比較(コロニーカウント法)
標準コース
温水180分

菌が少ない※3
※3 画像上は見られませんが、すべての原因菌が除去されているものではありません。
※すべての黄ばみやニオイの原因菌を除去できるわけではありません。 ※黄ばみを除去し、ニオイを抑制する温水180分では、粉末合成洗剤を通常の2倍使用します。

温めた高濃度洗剤液を浸透させ、衣類を約30~40℃に温めます。洗剤の酵素パワーを引き出すことで、黄ばみを落とし、ニオイも抑えます。

標準コースと比べて
| 追加時間 | 容量の上限 | 洗剤量 | 追加使用水量 | 追加消費電力量 | ||
|---|---|---|---|---|---|---|
| 温水180分 | 黄ばみの除去 ニオイの抑制 |
180分 | 2kg | 通常の2倍 | 50L | 1,300Wh |
| 温水90分 | 黄ばみの予防 | 90分 | 5kg※4 | 通常 | - | 500Wh |
| 温水180分 | 温水90分 | |
| 黄ばみの除去 ニオイの抑制 |
黄ばみの予防 | |
| 追加時間 | 180分 | 90分 |
|---|---|---|
| 容量の上限 | 2kg | 5kg※4 |
| 洗剤量 | 通常の2倍 | 通常 |
| 追加使用水量 | 50L | - |
| 追加 消費電力量 |
1,300Wh | 500Wh |
※4 温水90分の容量の上限は、BW-DX90J:4.5kg、BW-DV80J:4kg。
| 試験方法 | 除菌・消臭方法 | 対象部分 | 試験結果 | |
|---|---|---|---|---|
| ※1 | 部屋干し臭が付着したタオルの6段階臭気強度表示法にて官能評価 | 温水 180分による |
洗濯した衣類 | 〈臭気強度〉 標準コース:3.5、温水180分:1.5(DX120J) 標準コース:3.5、温水180分:1.7(DX100J・DX90J・DV80J) |
| ※2 | 菌を塗布した試験布の菌の減少率測定 | 温水 180分による |
洗濯した衣類 | 菌の減少率99% |
| ※1 | ※2 | |
| 試験方法 | 部屋干し臭が付着したタオルの6段階臭気強度表示法にて官能評価 | 菌を塗布した試験布の菌の減少率測定 |
| 除菌・消臭 方法 |
温水 180分による |
温水 180分による |
| 対象部分 | 洗濯した衣類 | 洗濯した衣類 |
| 試験結果 | 〈臭気強度〉 標準コース:3.5、温水180分:1.5(DX120J) 標準コース:3.5、温水180分:1.7(DX100J・DX90J・DV80J) |
菌の減少率99% |
※1 当社調べ。〈臭気強度〉5:強烈なニオイ、4:強いニオイ、3:楽に感知できるニオイ、2:何のニオイかがわかる弱いニオイ、1:やっと感知できるニオイ、0:無臭 ※2 ●試験依頼先:一般財団法人 北里環境科学センター ●報告書No.:北生発2022_0522号 ※時間の経過などにより変化する場合があります。
温水ナイアガラ ビート洗浄について ●衣類の取扱絵表示に従ってください。 ●傷みが気になる衣類は洗わないでください。色移りすることがありますので、色柄物と白物は分け洗いをしてください。 ●日光などで変色した黄ばみは落ちません。
寒い日は衣類を温め、
洗浄力をキープします。
「温め自動」モード
水温13℃以下のとき、衣類に温風を吹きつけ、洗剤の酵素パワーを引き出して洗浄力を高めます。1度の設定で毎回作動します。
※追加消費電力量:150Wh(BW-DX120J)、110Wh(BW-DX100J・DX90J・DV80J)、追加時間:16分。



すすぎ前の水
白濁している

すすぎ後の衣類をしぼって出た水の比較※5
どちらも一見透明に見えるが
洗剤成分の一部が青白く見える

すすぎ後の衣類をしぼって出た水の比較※5





※5 当社調べ。BW-DX120J、定格負荷洗濯時、標準コースにおいて。すすぎ後の衣類をしぼって出た水に含まれるアルカリ濃度相当量の粉末洗剤水溶液にて比較。衣類の量、汚れ、洗剤の種類、水温、室温などによって効果は異なります。

たっぷりの水を循環させる[ナイアガラシャワー]や、強い遠心力を生み出す高速回転などの技術で、汚れや繊維に潜んだ洗剤まで徹底的にすすぎます。
ナイアガラすすぎオフ時、標準コースと比べて
| 追加使用水量 | 追加消費電力量 | 追加運転時間 | |
|---|---|---|---|
| DX120J 洗濯12kg時 |
88L | 91Wh | 30分 |
| DX100J 洗濯10kg時 |
88L | 62Wh | 28分 |
| DX90J 洗濯 9kg時 |
79L | 61Wh | 28分 |
| DV80J 洗濯 8kg時 |
76L | 61Wh | 28分 |
〇このページは、BW-DX120J、BW-DX100J、BW-DX90J、BW-DV80Jの特長を紹介しています。
〇BW-DX120Jで説明しています。他の機種は、形状・構造・効果が異なります。
〇画面上の商品の色は、実際の色とは異なる場合があります。
衣類の量や種類、片寄り、室温、据付状態等により、使用水量・消費電力量・運転時間が増減します。